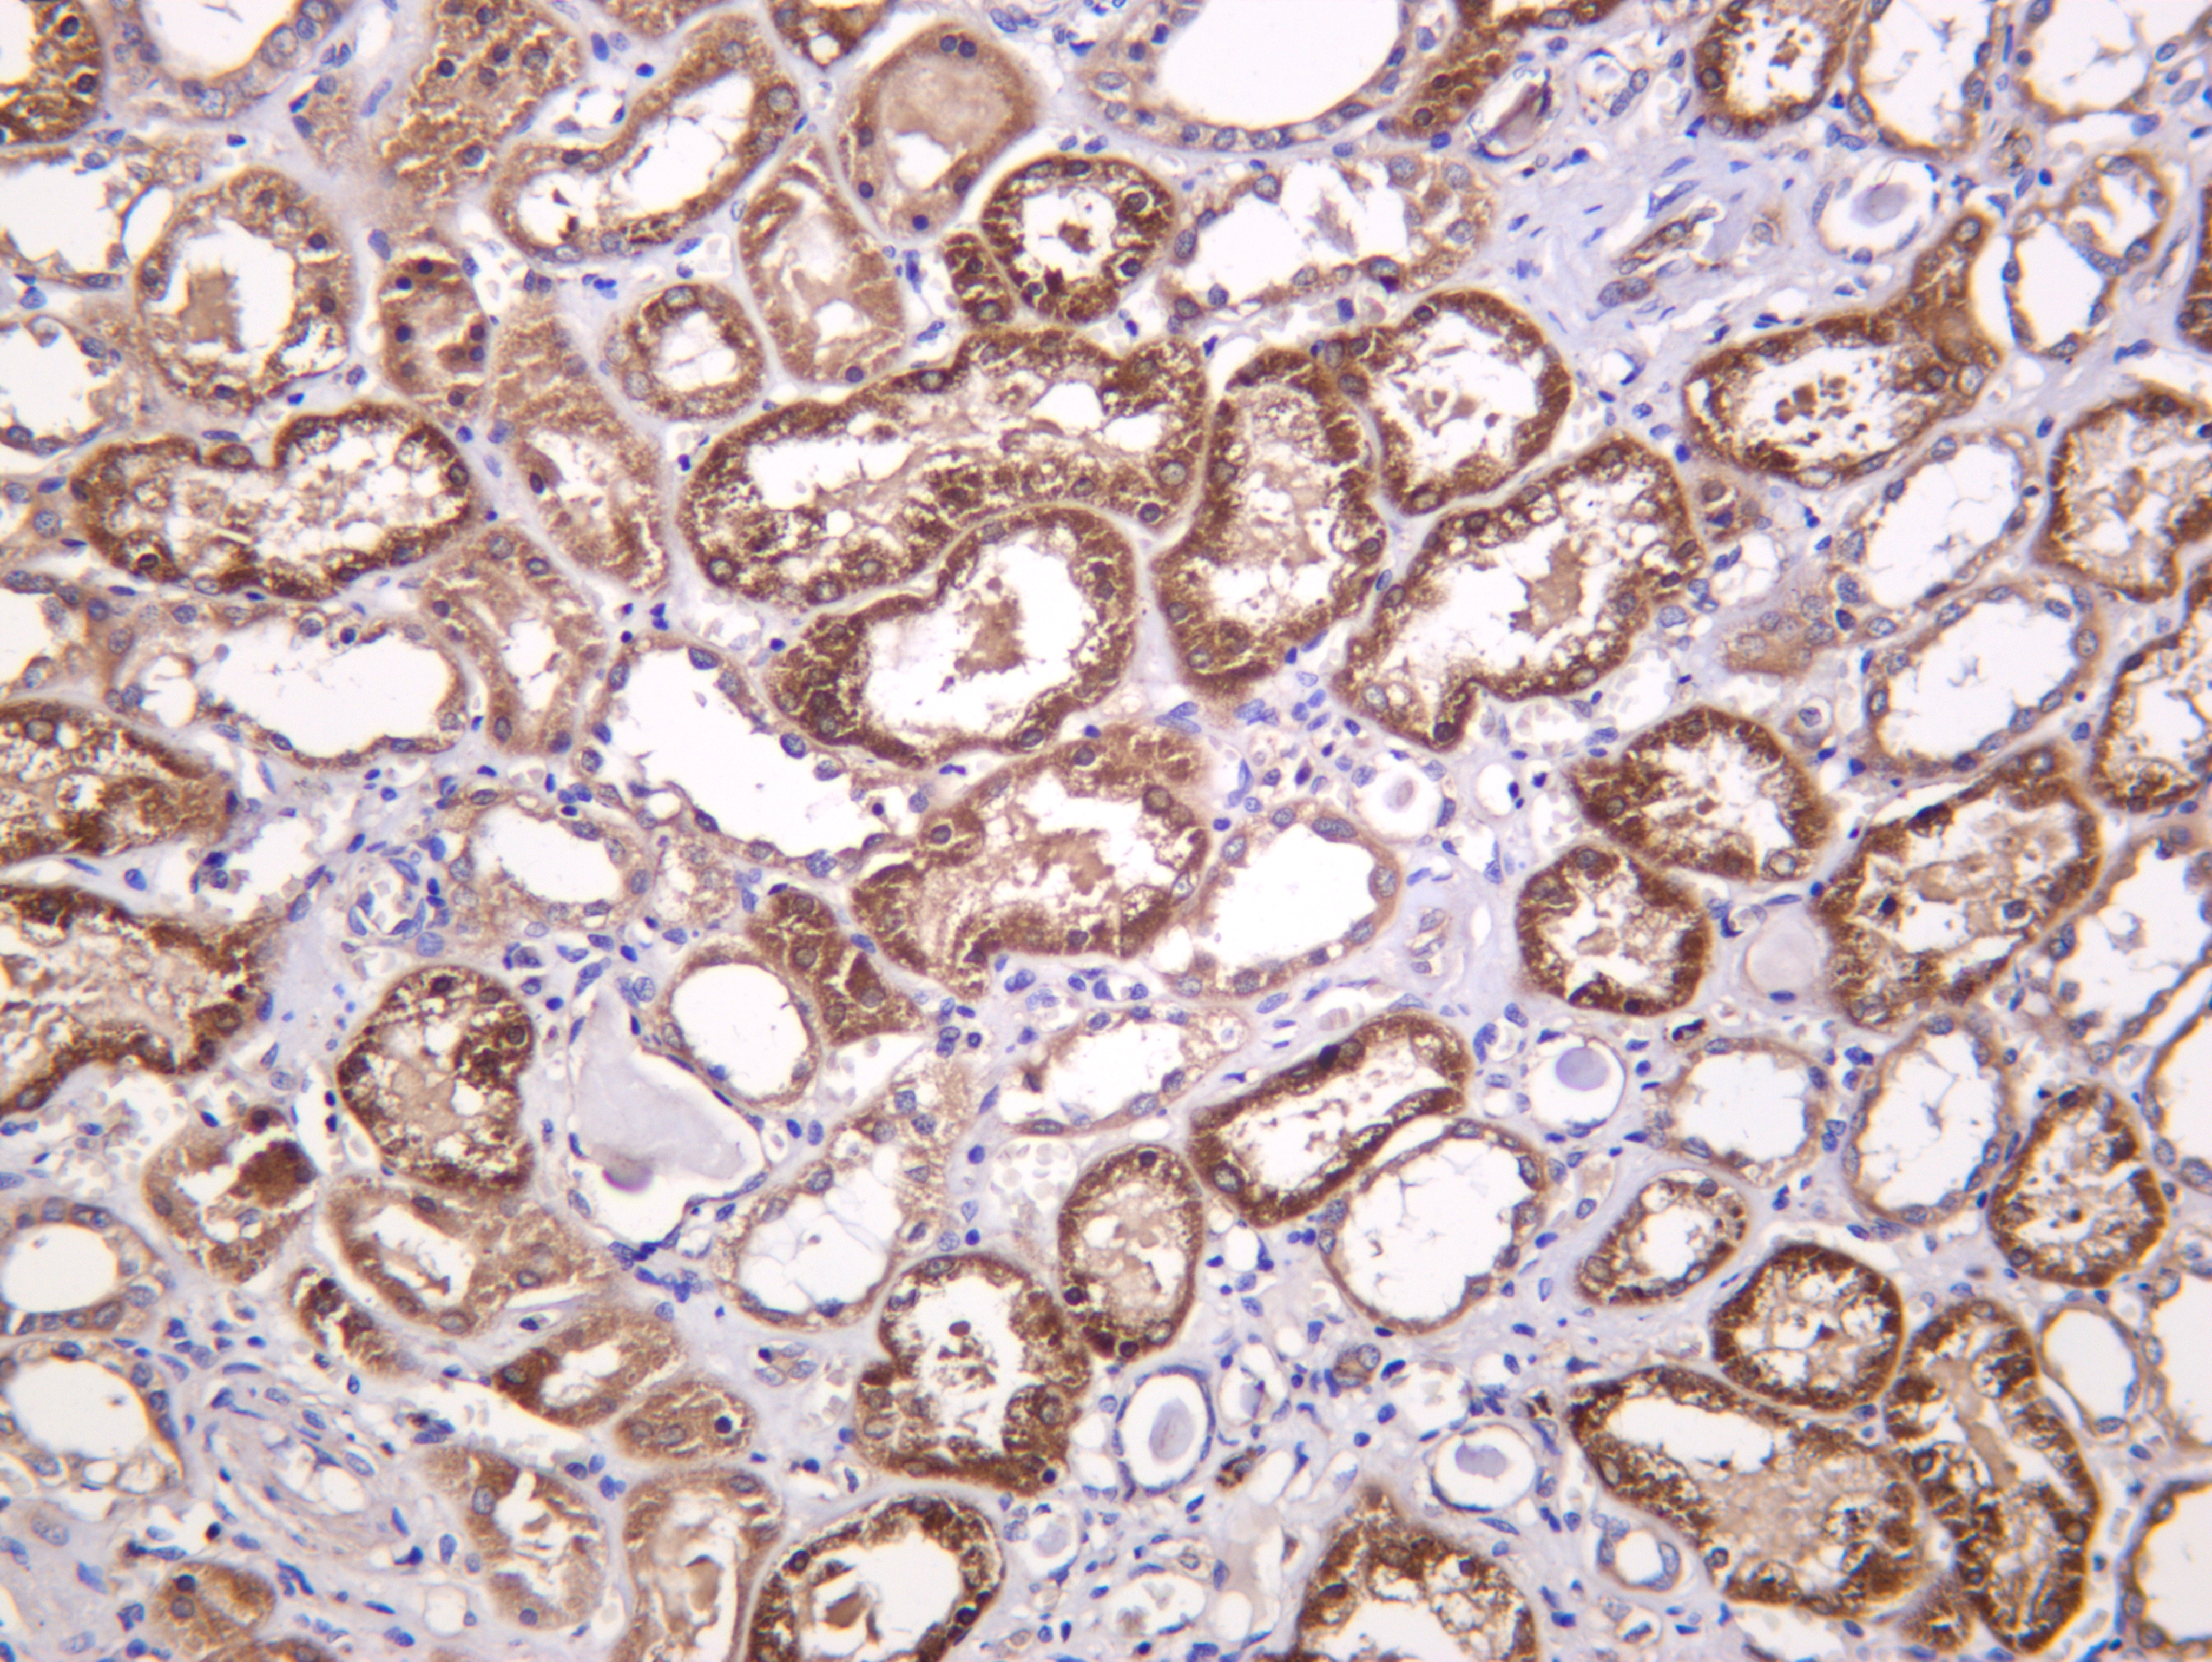

收藏
收藏
| 规格 | 价格 | 货期 | 数量 |
|---|
|
Immunohistochemical analysis of paraffin-embedded Human kidney |
 |
Immunohistochemical analysis of paraffin-embedded Mouse kidney |

 电话咨询
电话咨询
 在线咨询
在线咨询
 QQ
QQ
 二维码
二维码
 扫码二维码
扫码二维码